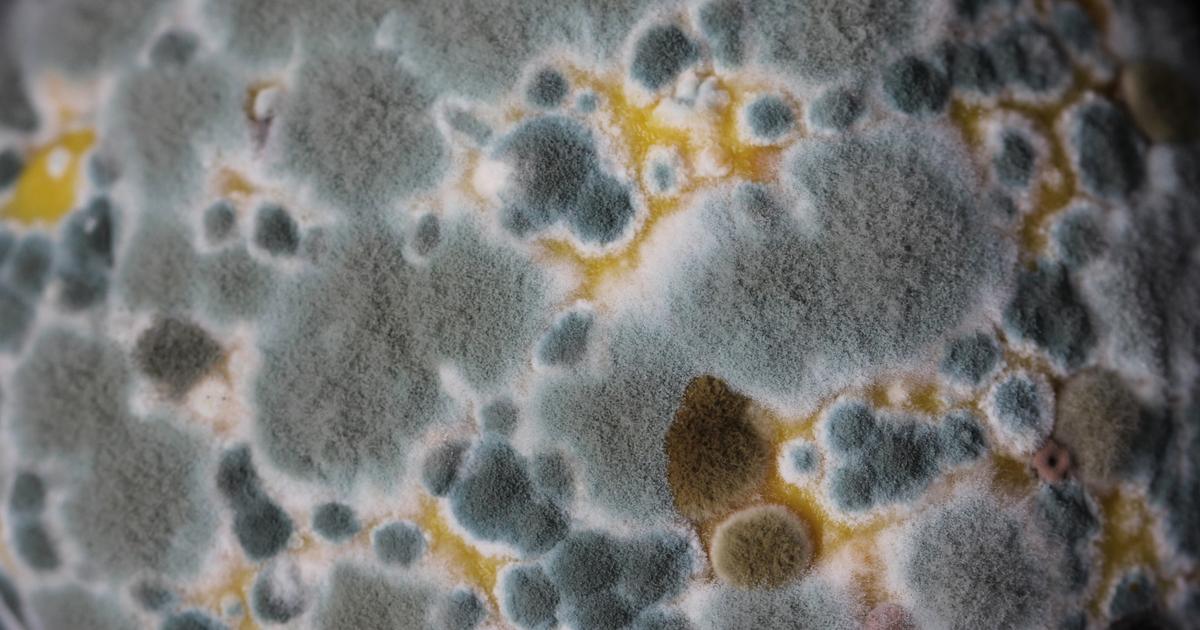
Shelf life simplified

Knowledge base
Expertise Library

Moisture content vs water activity: Choosing the right measurement
Moisture content and water activity have to do with water, but the distinction isn’t always clear. Learn why to measure moisture content and water activity.

Measuring moisture content: It’s more complicated than you think
[Learn how] In theory, moisture content (MC) measurement is easy. Simply determine the amount of water in a product, and compare that to the weight.

Examining powder stability: Physical, chemical & microbial
Most people intuitively know what a powder is. They’re everywhere. We interact with them daily. But with so many different categories of powder – spices, ingredients, cosmetics, pharmaceutical excipients and APIs, and countless others – it can be tough to define and resolve specific issues.

Volatile ingredients & water activity: Choosing the right sensor
When measuring the water activity (also known as aw, RH, ERH, or vapor pressure) of a product, certain ingredients – volatile compounds – can cause problems. Some water activity sensors are better protected against volatiles than others. So how much protection do you need?

Which moisture balance is perfect for you?
[Read more] Trying to pick the perfect moisture balance out of the many options? It can be daunting to choose the best moisture analyzer.

Calculating the change in energy for food scientists
A change in energy comes with a change in vapor pressure. Let's break down how the first law of thermodynamics can help calculate the amount of change.

How to optimize food drying, baking or dehydrating
Most food companies know they could optimize their drying processes to some degree. But almost all of them underestimate what they’d gain by doing so – and what they lose by ignoring problems.

Real-time data for process control in food manufacturing
Most companies log data. Only the best use it to their competitive advantage. The right tools can transform data into a profitable course of action.

Managing moisture variability in dried fruits and nuts
Fruits and nuts appeal to consumers, who love seeing familiar foods on ingredient lists. But working with natural products can be tricky.

How to control lipid oxidation in food manufacturing
What if there was a way to control how quickly your products went rancid and bitter? Turns out there is – water activity is the answer.

What is a moisture analyzer? How do balances, ovens, titrations and NIR compare?
A moisture analyzer determines the moisture content of a sample. There are several types of moisture content (Mc) instruments.

How to predict moisture migration with water activity
Water activity, not water content, predicts how water will migrate. Knowing your water activity levels helps you determine how to formulate and package.

Predict packaging performance to maximize product shelf life
You only need two key metrics to evaluate packaging: water activity and package permeability. Let's explore how to use them and why they're important.

Use water activity to get—and maintain—the right texture
[Expertise library] Candy, confectionery, chips and snacks – without the right texture, food loses its appeal. Aw helps you nail the perfect texture.
Shelf life simplified
Shelf life testing can be overwhelming, time-consuming, and expensive. Water activity measurements offer a far easier and more affordable way. Here's why.

Using hurdle technology for safer and fresher food
Less processing plus longer-term preservation – hurdle technology offers big benefits. But which of the 50+ hurdles is right for you?

Water activity definition
Water activity is defined as the ratio of the vapor pressure of water in a material (p) to the vapor pressure of pure water (po) at the same temperature.

Dynamic Vapor Sorption 101: What, why and how?
The water in food and pharma products impacts how they’re used, when they degrade, and more. Moisture can’t be safely ignored – so how can its impact be measured and accounted for?

Water activity USP 922 standard in pharma
[Read about the new standard —US Pharmacopeia USP ] With water activity’s greater popularity in pharmaceutical has come new regulations and standards.

Water activity before and after freezing
Does a food product's water activity level change when frozen? What about thawed? After a month of research and testing, here's what our scientists said.

How water activity and pH work together to control microbial growth
[Science delivered] Water activity and pH are two measurements that are better together. Use commercial instruments to simplify your workflow.

Water activity for food safety and quality
Water activity is the leading parameter for food quality and safety by controlling microbial growth, prevent caking and clumping, determine shelf life, and plenty more.

Government regulations recommend water activity measurements in food
Regulatory bodies around the globe require the use of water activity. We've compiled a complete regulation reference list.

How water activity controls microbial growth
Destroy delays with our fast moisture content analyzers. Get both water activity and moisture content readings in less than one minute.